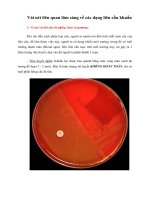
Vài nét liên quan lâm sàng về các dạng liên cầu khuẩn

VIÊM HỌ NG DO LIÊN CẦU KHUẨN NHÓM A ppt
Bạn đang xem bản rút gọn của tài liệu. Xem và tải ngay bản đầy đủ của tài liệu tại đây (183.66 KB, 7 trang )
VIÊM HỌ NG DO LIÊN CẦ U KHUẨ N
NHÓM A
Hoàng Trọng Kim
TÓM TẮT :
Viêm họng do liên cầu khuẩn nhóm A là một bệnh thường gặp ở trẻ em và có hậu quả nghiêm
trọng là thấp tim, có thể gây tử vong ngay hoặc để lại di chứng ở van tim rất nặng. Về dịch tễ
học, bệnh nhiễm LCK nhóm A đã giảm nhiều sau Thế chiến thứ II, nhưng lại bùng phát vào
thập niên 80 do sự xuất hiện của các chủng LCK mới có độc lực và khả năng gây bệnh cao.
Chẩn đoán viêm họng do LCK nhóm A được dựa trên lâm sàng, cấy họng và test chẩn đoán
nhanh LCK. Pénicilline là thuốc chọn lọc để điều trị LCK nhóm A. Chỉ cần 1 liều Benzathine
pénicilline tiêm
bắp thịt, hoặc uống 10 ngày Pénicilline V, hoặc Erytromycine, hoặc Cephadroxyl ; hoặc 5 ngày
Azithtromycine là đủ để điều trị 1 đợt viêm họng do liên cầu. Ðể phòng ngừaviêm họng tái
phát chỉ cần Benzathine pénicilline tiêm thịt 3 tuần 1 lần, hoặc uống Sulfadiazine, hoặc
Pénicilline V mỗi ngày.
GROUP A STREPTOCOCCAL PHARYNGITIS
Hoang Trong Kim * Y học TP Ho Chi Minh, 1996, N). Special : 9 - 12
SUMMARY
Group A Streptococcal pharyngitis is a major illness suffered by humans, especially chldren. It
in a severe disease because of its serious cardiovascular sequelae. By the 1970, the
Streptococcal infections and rheumatic fever were rarely seen, but they began to emerge in the
1980s because of the appearance lf certain serologic types of Group A Streptococci. The
Diagnosis of Streptococcai pharyngitis is based on the clinical signs, the positive throat culture
and the positive rapid Strep test. Penicillins are the drugs of choice in the management of the
Streptococcal pharygitis. A single dose of Benzathine penicillin intramuscular, or oral Pénicilline
V are the standard for therapy of Strep pharyngitis. Oral Erytromycin (10 days) Cephadroxyl
(10 days), or Azithtromycine (5 days) are also effective. The prevention regiments of choice
are Benzathine penicilline intramuscular administered every 3 weeks or oral Penicillin V or oral
Sulfadiazine administered daily for patients alergic to Penicilline.
Viêm họng là bệnh rất phổ biến, chiếm tỷ lệ hàng đầu trong số lần khám tại các tuyến y tế,
nhất là các phòng khám nhi khoa
1,2,3,4,5,6
. Về nguyên nhân, tuy chiếm đa số (75%) nhưng viêm
họng do Virus là một bệnh nhân rất lành tính ; chỉ có viêm họng do liên cầu khuẩn nhóm A,
tuy ít hơn (25%) nhưng rất nguy hiểm, vì có thể đưa đến viêm cầu thận cấp, đặc biệt là thấp
tim có thể
gây tử vong ngay, hoặc để lại di chứng ở van tim rất năng, biến trẻ thành người tàn tật suốt đời
2,3,4,5,8,9,15,16
.
Ðây là một bệnh đã gây nhiều bàn cãi trong suốt mấy thập niên vừa qua về tất cả các mặt
dịch tễ học, chẩn đoán, điều trị và chiến lược phòng ngừa
1,2,4,8,9,14,15,16
.
VỀ DỊCH TỄ HỌC
Không như những bệnh khác, bệnh nhiễm liên cầu nhóm A có nhiều thay đổi trong hơn 30
năm qua. Trước khi kháng sinh ra đời, nhiễm liên cầu khuẩn là một tai họa của loài người, với
nhiều bệnh rất nặng có tử vong cao. Sau Thế chiến thứ II, sự xuất hiện của kháng sinh, kinh tế
phát triển, mức sống được nâng cao, môi trường sống được cải thiện, chăm sóc y tế tốt hơn
đã làm giảm đáng kể tần suất các bệnh do liên cầu khuẩn gây ra như nhiễm trùng huyết, tinh
hồng nhiệt, nhiễm trùng hậu sản, hội chứng sốc nhiễm độc nhiễm trùng, viêm cầu thận cấp,
t
hấp tim,. Nhưng đến năm 1987, bệnh nhiễm liên cầu tan huyết b nhóm A và hậu quả của nó
là thấp tim lại bùng phát ở Mỹ và một số nước khác
1,2,4,6,8
. Ngaysau đó, nhiều công trình
nghiên cứu được thực hiện, đã tìm ra nguyên nhân của sự bùng phát này là do lơi lỏng trong
các biện pháp phòng ngừa và sự xuất hiện của nhiều chủng mới liên cầu tan huyết b nhóm A
có độc lực mạnh hơn. Trong thập niên 70, các liên cầu tan huyết b nhóm A gây bệnh thuộc
nhóm huyết thanh
M4, 12 nhưngđến thập niên 80, các nhóm liên cầu khuẩn M
1,3,5,18
có độc lực nhiều, có khả
năng
gây bệnh cao là thủ phạm chính đã gây ra sự bùng phát của viêm họng và thấp khớp, thấp tim,.
VỀ CHẨN ÐOÁN
Trong công tác hàng ngày, các bác sĩ nhi khoa phải kết hợp nhiều yếu tố dịch tể, lâm sàng,
cận lâm sàng để chẩn đoán phân biệt giữa viêm họng do liên cầu khuẩn và viêm họng do
các nguyên nhân khác mà đặc biệt là do Virus. Nhờ các triệu chứng lâm sàng kinh điểm,
một bác sĩ nhiều kinh nghiệm có thể chẩn đoán được viêm họng do liên cầu khuẩn, nhưng
muốn xác định chắc chắn thì phải cấy họng hoặc dùng test chẩn đoán nhanh nhiễm liên
cầu.
Trên lâm sàng
Có thể nghĩ đến viêm họng do liên cầu khuẩn khi thấy một trẻ tuổi từ 5 đến 15, vào lúc tiết
trời mưa lạnh hoặc ở mùa xuân, mùa đông, đến khám bệnh vì sốt cao đột ngột, đau họng,
nhức đầu, đau bụng, khi khám thấy họng đỏ, hai hạch nhân to, sần sùi, tiết dịch, hạch ở cổ
và dưới hàm sưng to và đau. Tuy nhiên, các dấu hiệu lâm sàng điển hình này không phải
lúc nào cũng có, mà đa số viêm họng do liên cầu thường không có hoặc có rất ít triệu
chứng lâm sàng, nên
thường bị bỏ sót, hoặc chẩn đoán nhầm với nguyên nhân khác. Viêm họng do Virus điển hình
thường có sốt cao kèm theo ho, chảy nước mắt, nước mũi, tiêu chảy và có yếu tố dịch tể kèm
theo như đang mùa cảm cúm, (xem bảng 1).
Cấy dịch ở họng
Dùng que bông phết họng, lấy chất dịch ở vùng nách sau của họng và xung quanh 2 hạch hạnh
nhân, đem cấy trong dĩa thạch pha huyết bò. Nếu làm đúng kỹ thuật, tỷ lệ dương tính lên đến
90 - 97%. Phương pháp nuôi cấy vi trùng cho phép chẩn đoán chắc chắn là viêm họng do
liên cầu tan huyết b nhóm A
2,3,4,8,9
Tri
ệ
u
c
h
ứ
n
g
VH
d
o
li
ê
n
c
ầ
u
VH
d
o
V
i
ru
s
M
ù
a
Ð
ô
n
g,
x
u
â
n
,
mưa
l
ạ
n
h
T
h
ay đ
ổ
i
Tuổi 3 - 20 tuổi Bất
kz
Khởi phát Ðột ngột Từ từ
D
ấ
u
h
i
ệ
u
b
a
n
đ
ầ
u
Ð
au
h
ọ
n
g
k
h
i
n
u
ố
t
N
g
ứ
a
h
ọ
n
g
h
ơn là
đau
Kh
á
m
h
ọ
n
g
Ð
ỏ
,
p
h
ù
,
ti
ế
t
,
d
ị
c
h
và
n
g
Ð
ỏ
,
lo
ét
,
t
i
ế
t
d
ị
c
h
t
r
o
n
g
H
ạ
ch
c
ổ
dư
ớ
i
h
à
m
Sưng
t
o
và đau
To
h
o
ặ
c
k
h
ô
n
g
D
ấ
u
h
i
ệ
u
ở
d
a
N
ổ
i
h
ồ
n
g
b
a
n
N
ổ
i
m
ẩ
n
,
b
ó
n
g
nư
ớ
c
Tri
ệ
u
c
h
ứ
n
g
k
h
á
c
Nh
ứ
c
đ
ầ
u
,
đau
b
ụ
n
g
H
o,
c
h
ả
y
n
ư
ớ
c
m
ắ
t
,
n
ư
ớ
c m
ũ
i,
t
iêu
chảy
Bảng 1 : Tóm tắt chẩn đoán phân biệt viêm họng do liên cầu và viêm họng do virut
Test chẩn đoán nhanh liên cầu khuẩn nhóm A :
Trên thị trường hiện nay, có khoảng 30 viện bào chế đã sản xuất các bộ test khác nhau,
nhưng tất cả đều dựa trên nguyên tắc chung là dùng phản ứng miễn dịch để phát hiện các
kháng nguyên chứa trong vỏ bọc của liên cầu khuẩn tan huyết b nhóm A
2,8,9,14
. Ưu điểm của
các test chẩn đoán nhanh này là có tính chuyên biệt rấtcao 98,1%. Khi test dương tính chẩn
đoán chắc chắn là nhiễm liên cầu khuẩn tan huyết b nhóm A
2,9,14
. Lợi điểm củatest này là
tiết kiệm được rất nhiều thời gian, trong khi phải chờ từ 24 đến 48 giờ mới có kết quả nuôi
cấy, thì chỉ cần khoảng 10 phút, nếu test dương tính thì chẩn đoán đã xác định và bắt đầu
điều trị ngay
4,5,8,12,14,16
làm cho chẩn đoán bị bỏ sót.Tuy nhiên test này cũng có điều bất lợi là tính nhạy cảm
hơi thấp, 90 - 92%. Với 8 - 10% âm tính, trong đó có thể có những trường hợp âm tính giả
2,49,14,16
làm cho chẩn đoán bị bỏ sót. Vì thế khi test âm tính nên xác định chẩn đoán thêm
bằng nuôi cấy vi trùng
2,4,5,9,13
.
VỀ ÐIỀU TRỊ :
Trước khi có kháng sinh, liên cầu khuẩn là một tai họa lớn, gây nhiều tử vong trong các thể
bệnh nặng cấp tính như nhiễm trùng huyết, tinh hồng nhiệt,áp xe phổi, áp xe sau thành
họng, hội chứng nhiễm độ nhiễm trùng, Và để lại nhiều di chứng rất nặng sau viêm họng
như thấp tim, viêm cầu thận cấp,.
Hiện nay, việc sử dụng kháng sinh rộng rãi đã làm giảm tần suất và tử vọng của các thể cấp
tính, nhưng nguy hiểm của bệnh nhiễm liên cầu khuẩn tan huyết b nhóm A vẫn còn, với rất
nhiều trẻ bị viêm họng rồi có thể bị bệnh van tim hậu thấp rất nặng hoặc tử vong hoặc trở
thành tàn tật, mà việc điều trị còn rất tản mạn. Nhiều người còn dùng kháng sinh chưa đúng
loại, chưa đủ
liều, chưa đủ thời gian làm cho điều trị thất bại và lãng phí.
Ðối với liên cầu khuẩn tan huyết b nhóm A, chỉ cần một số ít kháng sinh thuộc nhóm
Penicilline, Cephalosporine, hoặc Macrolide là đủ.
-
Penicilline là thuốc chọn lọc đầu tiên, rất hữu hiệu, rẻ tiền, cách dùng đơn giản. Cho tới nay,
chưa có một tài liệu nào nói đến việc kháng thuốc của liên cầu khuẩn tan huyết b nhóm A đối
với Penicilline
4,5,9,10,12,16
. Chỉ cần 1 liều duy nhất Benzathine penicilline tiêm bắp thịt, 600.000
đơn vị cho trẻ dưới 30 kg, hoặc 1.200.000 đơn vị, cho trẻ trên 30 kg là đủ để điều trị 1 đợt
viêm
họng do liên cầu
3,4,5,8,9,12,13,16
.
Nếu vì 1 l{ do nào đó mà không chích được, thì cho uống penicilline V liên tục trong 10 ngày,
200.000 đơn vị x 2 / ngày cho trẻ dưới 30 kg hoặc 400.000 đơn vịx 2 / ngày cho trẻ trên 30
kg. Ðiều quan trọng là phải uống đủ ngày
2,3,4,8,9,12,16
, nhưng trên thực tế ít khi bệnh nhân
uống đủ
10 ngày, vì chỉ sau 2, 3 ngày là các triệu chứng lâmsàng đã bớt, bệnh nhân tưởng bệnh đã
lành, nên ngưng thuốc. Ngoài ra, nhiều công trình đã chứng minh chích Benzathine pencilline
có kết quả cao hơn uống penicilline V
2,8,9,13,16
. Do đó, chúng ta nên động viên cán bộ y tế và
giải thích cho nhân dân mạnh dạn chích Benzathine pencilline, vì khi chích, thỉnh thoảng cũng
bị sốc phản vệ có thể tử vong, nhưng với tỷ lệ rất thấp, 0,03%
2,8,9,16
thì rất không đáng kể
sovới tác hại quá lớn do thấp tim gây ra.
- Một số thuốc trong nhóm C phalosporine như cefadroxil, cefuroxime, cefexime,cesprozil,
cepodoxime cũng có tác dụng khá hơn penicilline một chút, nhưng giá đắt hơn rất nhiều,
nên không được sử dụng rộng rãi 5,6,9.
- Macrolide được dùng khi bệnh nhân bị dị ứng với penicilline :
+ Erythromycine 30 mg/kg/ngày uống trong 10 ngày, cho kết quả không bằng penicilline, vì
có tài liệu cho rằng erythromycine đã bị kháng thuốc từ 20 - 40%
2,4,5,6,7,18
.
+ Azithromycine là kháng sinh duy nhất được tổ chức kiểm soát thuốc và thực phẩm Hoa
k
z
(FDA) công nhận có hiệu quả trong điều trị viêm họng do liên cầu khuẩn chỉ trong 5 ngày
5,8,9 với liều duy nhất cho người lớn là 500mg trong ngày đầu và 250mg/ngày trong 4 ngày
kế tiếp.
Tóm lại, Hội nhi khoa và hội tim mạch Hoa kz đề nghị phác đồ điều trị viêm họng do liên
cầu khuẩn tan huyết b nhóm A
5,8,9
như sau :
+ Benzathine penicilline liều duy nhất, tiêm bắp thịt :
. 600.000 đơn vị cho trẻ dưới 30 kg.
. 1.200.000 đơn vị cho trẻ > 30kg.
+ Hoặc Pencilline V uống liên tục trong 10 ngày :
. 200.000 đơn vị x 2 / ngày cho trẻ dưới 30 kg.
. 400.000 đơn vị x 2 / ngày cho trẻ trên 30 kg.
+ Nếu dị ứng với Penicilline, cho Erythromycine 30mg/kg/ ngày uống liên tục trong 10 ngày,
nếu
Erythromycine bị kháng, cho Azithromycine 500mg/kg/ngày đầu và 250mg/kg/ngày trong
4 ngày nữa.
+ Hoặc Cephadroxil 30mg/kg liều duy nhất/ngày x 10 ngày.
VỀ PHÒNG NGỪA :
Ðối với trẻ bị viêm họng tái phát nhiều lần, nên phòng ngừa bằng
5,9,13,15
:
+ Benzathine Penicilline tiêm bắp thịt, 3 tuần 1 lần : 600.000 đơn vị cho trẻ dưới 30 kg
1.200.000 đơn vị, cho trẻ trên 30kg.
+ Hoặc như Sulfadiazine uống liên tục, mỗi ngày 1 lần : 0,5g cho trẻ dưới 30kg ; 1g cho trẻ trên
30kg.
+ Hoặc Penicilline V uống mỗi ngày : 200.000 đơn vị x 2 cho trẻ dưới 30 kg, 400.000 đơn vị x
2 cho trẻ trên trên 30 kg.
Hiện nay văcxin chủng ngừa liên cầu khuẩn ta huyết b nhóm A đã thực hiện thành công,
nhưng giá rất cao và phải có nhiều loại vắcxin khác nhau cho các loại liên cầu có típ huyết
thanh M khác nhau, nên chưa chủng ngừa được bệnh nhiễm liên cầu. Vì thế, chúng ta phải
tăng cường công tác giáo dục y tế cho nhân dân để họ hiểu rõ tác hại lớn của thấp tim và
bệnh van tim hậu thấp, chính là hậu quả của viêm họng do liên cầu khuẩn tan huyết b nhóm
A, để mọi người tích cực đề phòng và điều trị triệt để căn bệnh tuy nhẹ ở họng, mà để lại di
chứng rất nặng ở tim này.
TÀI LIỆU THAM KHẢO :
1. EDWARD L. KAPLAN, 1994, Understanding group A steptococcal infections in the 1990s :
proceedings of asymposium. Pediatr Infect Dia J. 13 : 556 - 557.
2. STANFORD SHUMLMAN, 1994, Streptococcal pharyngitis : diagnostic considerations Pediatr
Infect Dia J. 13 : 567 - 571.
3. MILTON MARKOWITS, 1994, Changing epidemiology of group A
streptococcalInfections, Pediatr Infect Dia J. 13 : 557 - 560.
4. DENNIS L. STEVENS, 1994, Invasive groupA streptococcal Infections : the past, present
and future, Pediatrr Infect Dia J. 13 : 561 - 566.
5. JEROME O. KLEIN, 1994, Management of Streptococcal pharyngitis, Pediatr Infect Dia J. 13 :
572 - 575.
6. STODDARD JEFFREY, ST. PETER, ROBERT F., 1994, Health insurance statusand
ambulatorycare for chldren, The new England journal of Medicine, 330 : 1421- 1425.
7. WALDO E. NELSON, 1996, infections of the upper respiratory tract, in : Nelsons textbook
of pediatrics, 15 th Edition, pp 1187 - 1192, W.B. Saunders company, Philadelphia.
8. FLOYD W. DENNY, 1993, Group A streptococcal Infections, Currunt Problems in
Pediatrics, May - june 1993 : 179 - 184.
9. ANGELO TARANTA, MILTON MARKOWITZ, 1989, Rheumatic fever, second edition, pp 5 -
82, Kluwer academic publishers, Boston.
10. FRANK A. DISNEY, HUGH DILLON, JEFFREYL. BLUMER, 1993, Cephalexin and penicilline in
the treatment of group A streptococcal throat infections, jama sea ferruary 1993 : 31 - 35.
11. OBRIEN THOMAS, 1992, Global suveillance of antibiotic resistance, The new England
journal of medicine, volume 326: 339 - 341.
12. MACHAEL A. GERBER, 1984, Treatment faillures and carriers : perception or problem
? Pediatr Infect Dia J. 13 : 576 - 579.
13. APPLIED BIOTECH INC, 1994, Surestep strep A TEST, San Diego, California.
14. HOANG TRONG KIM, 1995, Nghiên cứu bệnh thấp tim trẻ em và sách lược phòng
chống, Luận án phó tiến sĩ khoa học y dược, Trường ÐHYD TPHCM.
15. EDWARD L. KAPLAN, 1994, Public health implications of group a streptococcal infections
in the 1990s, Pediatr Infect Dia j. 13 : 580 - 583.
16. DAVID W. TEELE, 1994, Streptococcal pharyngitis : perplexity and precision in
diagnosis, Medical progress November1994 : 15 - 19